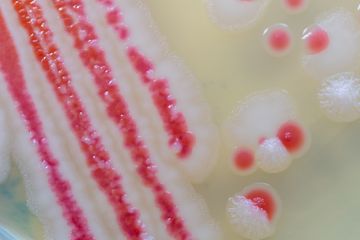
What is pink mold and how to get rid of it | Homes and Gardens

Pink Fungus/mold
Study the characteristics of Pink Fungus/mold using our comprehensive set of substantial collections of learning images. designed to support various learning styles and educational approaches. supporting curriculum development and lesson planning initiatives. Each Pink Fungus/mold image is carefully selected for superior visual impact and professional quality. Excellent for educational materials, academic research, teaching resources, and learning activities All Pink Fungus/mold images are available in high resolution with professional-grade quality, optimized for both digital and print applications, and include comprehensive metadata for easy organization and usage. Our Pink Fungus/mold images support learning objectives across diverse educational environments. Instant download capabilities enable immediate access to chosen Pink Fungus/mold images. Our Pink Fungus/mold database continuously expands with fresh, relevant content from skilled photographers. Professional licensing options accommodate both commercial and educational usage requirements. Each image in our Pink Fungus/mold gallery undergoes rigorous quality assessment before inclusion. Diverse style options within the Pink Fungus/mold collection suit various aesthetic preferences. Regular updates keep the Pink Fungus/mold collection current with contemporary trends and styles. Time-saving browsing features help users locate ideal Pink Fungus/mold images quickly. Advanced search capabilities make finding the perfect Pink Fungus/mold image effortless and efficient.

























:max_bytes(150000):strip_icc()/GettyImages-996137968-3cf12c07d532460d8b63498cb9462c2f-67b1266fc3ad4dcf8444472cb7b1698e.jpeg)

























![Pink Mold In Shower - Dangers, Causes & Removal [GUIDE]](https://www.ultimatemoldcrew.ca/wp-content/uploads/2023/05/is-pink-mold-dangerous-how-to-get-rid-of-pink-mold-in-shower.jpg)








![Pink Mold In Shower - Dangers, Causes & Removal [GUIDE]](https://www.ultimatemoldcrew.ca/wp-content/uploads/2023/05/pink-mold-shower-get-rid-of-pink-mold-in-shower.jpg)